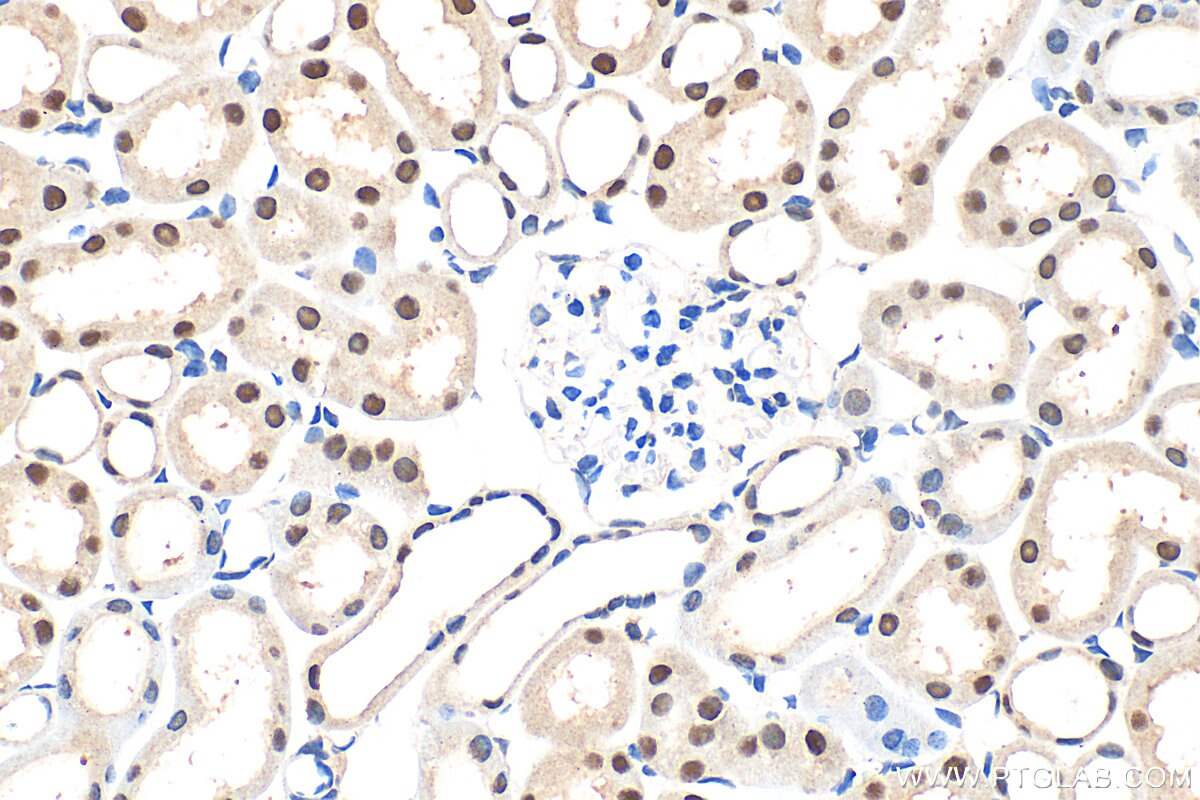
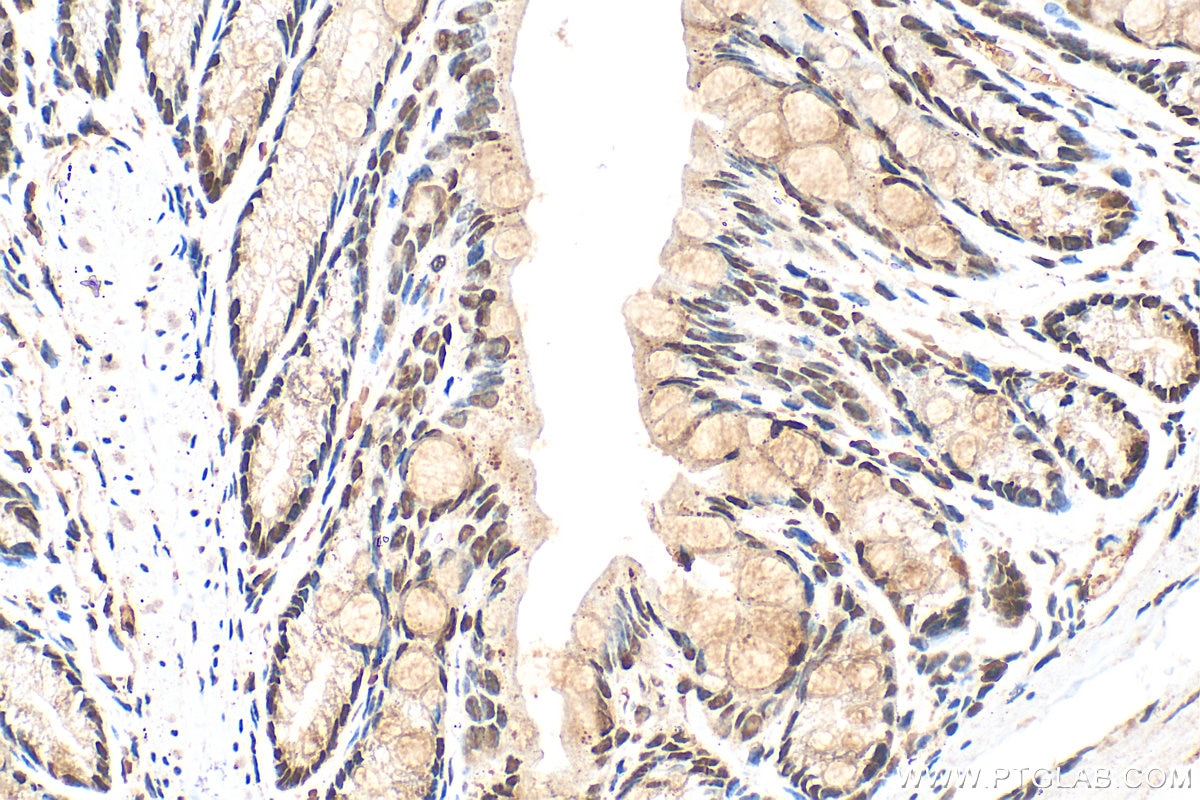

Tested Applications
| Positive WB detected in | A549 cells, HEK-293 cells, HeLa cells, HepG2 cells, Jurkat cells |
| Positive IHC detected in | mouse colon tissue, human breast cancer tissue, human colon tissue, mouse kidney tissue, mouse liver tissue, rat colon tissue, rat kidney tissue Note: suggested antigen retrieval with TE buffer pH 9.0; (*) Alternatively, antigen retrieval may be performed with citrate buffer pH 6.0 |
| Positive IF/ICC detected in | A431 cells |
Recommended dilution
| Application | Dilution |
|---|---|
| Western Blot (WB) | WB : 1:1000-1:6000 |
| Immunohistochemistry (IHC) | IHC : 1:50-1:500 |
| Immunofluorescence (IF)/ICC | IF/ICC : 1:50-1:500 |
| It is recommended that this reagent should be titrated in each testing system to obtain optimal results. | |
| Sample-dependent, Check data in validation data gallery. | |
Published Applications
| WB | See 1 publications below |
Product Information
25232-1-AP targets CCAR1 in WB, IHC, IF/ICC, ELISA applications and shows reactivity with human, mouse, rat samples.
| Tested Reactivity | human, mouse, rat |
| Cited Reactivity | human |
| Host / Isotype | Rabbit / IgG |
| Class | Polyclonal |
| Type | Antibody |
| Immunogen |
CatNo: Ag18970 Product name: Recombinant human CCAR1 protein Source: e coli.-derived, PET28a Tag: 6*His Domain: 217-343 aa of BC132725 Sequence: QPLLKTPPAVLQPIAPQTTFGVQTQPQPQSLLQAQISAASITPLLQTQPQPLLQQPQQKAGLLQPPVRIVSQPQPARRLDPPSRFSGRNDRGDQVPNRKDDRSRERERERRRSRERSPQRKRSRERS Predict reactive species |
| Full Name | cell division cycle and apoptosis regulator 1 |
| Calculated Molecular Weight | 1150 aa, 133 kDa |
| Observed Molecular Weight | 150 kDa |
| GenBank Accession Number | BC132725 |
| Gene Symbol | CCAR1 |
| Gene ID (NCBI) | 55749 |
| RRID | AB_3085778 |
| Conjugate | Unconjugated |
| Form | Liquid |
| Purification Method | Antigen affinity purification |
| UNIPROT ID | Q8IX12 |
| Storage Buffer | PBS with 0.02% sodium azide and 50% glycerol, pH 7.3. |
| Storage Conditions | Store at -20°C. Stable for one year after shipment. Aliquoting is unnecessary for -20oC storage. 20ul sizes contain 0.1% BSA. |
Background Information
Cell cycle and apoptosis regulator 1 (CCAR1) was originally identified from a functional screening and implicated in retinoid-induced cell cycle arrest and apoptosis. It has been shown that, in breast cancer cells, CCAR1 regulates apoptosis induced by various agents, including chemotherapeutics adriamycin, etoposide, and EGFR inhibitor. It is also involved in mediating anchorage-independent growth of colon carcinoma cells. In addition, CCAR1 plays the role as a co-activator of nuclear receptors to recruit mediator complex. It was found to associate with components of the Mediator and p160 coactivator complexes and is recruited to endogenous NR target genes. CCAR1 is also a binding partner of b-catenin and assists b-catenin in transcriptional activation of Wnt target genes.
Protocols
| Product Specific Protocols | |
|---|---|
| IF protocol for CCAR1 antibody 25232-1-AP | Download protocol |
| IHC protocol for CCAR1 antibody 25232-1-AP | Download protocol |
| WB protocol for CCAR1 antibody 25232-1-AP | Download protocol |
| Standard Protocols | |
|---|---|
| Click here to view our Standard Protocols |